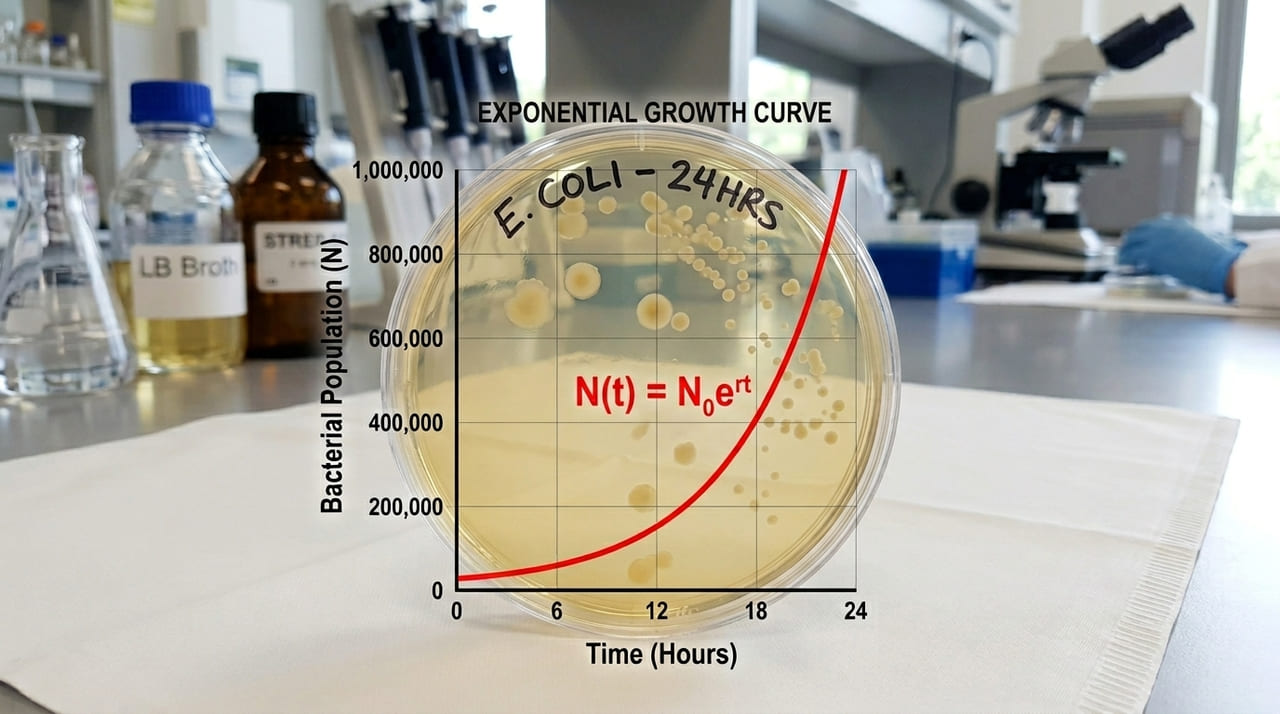
Cientistas identificaram um padrão matemático único que rege o ritmo da evolução e do gasto energético em todos os seres vivos.

Cientistas afirmam ter descoberto uma regra universal que “liga” a evolução e funciona da mesma forma em bactérias, plantas, répteis, peixes e insetos
A ciência revela uma regra matemática universal que governa a evolução de todas as espécies vivas do nosso planeta agora
A compreensão da vida na Terra acaba de ganhar um novo capítulo fascinante com a revelação de uma regra universal que conecta todos os seres vivos. Cientistas identificaram um padrão matemático que dita o ritmo da evolução e do metabolismo, funcionando de forma idêntica em bactérias e animais complexos. Este artigo revela como essa descoberta histórica redefine as fronteiras da biologia moderna e o que isso significa para o futuro do nosso planeta.
Por que essa regra universal é considerada um marco científico?
A descoberta de um padrão que rege desde microrganismos invisíveis até complexos ecossistemas representa um avanço sem precedentes na biologia teórica. Os pesquisadores conseguiram provar que existe uma lógica matemática subjacente ao crescimento e à adaptação das espécies ao longo do tempo geológico.
Essa uniformidade sugere que a evolução não é um processo puramente aleatório, mas sim um sistema que segue diretrizes estruturais bem definidas e previsíveis. Ao compreender esses mecanismos, a ciência abre novas portas para prever comportamentos biológicos em escalas que antes eram consideradas impossíveis de monitorar com precisão.
Quais são as espécies que seguem esse novo padrão biológico?
A abrangência desta nova regra biológica impressiona pela sua capacidade de atravessar diferentes reinos da natureza sem perder a precisão estatística. Independentemente da complexidade do organismo, a proporção encontrada entre o gasto de energia e a reprodução mantém uma constância admirável em todos os testes.
Os estudos realizados em laboratórios e as observações de campo confirmaram que a regra se manifesta de maneira clara em diversos grupos de seres vivos, como os listados a seguir:
- Colônias de bactérias que se adaptam rapidamente a novos tipos de ambientes.
- Plantas terrestres que equilibram perfeitamente o consumo de nutrientes e o crescimento.
- Répteis e peixes que seguem ritmos metabólicos específicos para a sobrevivência longa.
De que maneira o metabolismo influencia o ritmo da evolução?
O metabolismo funciona como o motor fundamental da vida, ditando a velocidade com que a energia é convertida em biomassa e descendência saudável. A nova regra demonstra que existe uma escala proporcional entre o tamanho do corpo e a eficiência energética de cada célula individual no organismo.

Esse equilíbrio delicado permite que as espécies otimizem suas chances de sobrevivência em condições climáticas variadas e em ambientes extremamente hostis. A harmonia encontrada entre o consumo de recursos e a produção biológica é o que garante a continuidade da vida em nosso ecossistema global.
Quais são as principais variáveis analisadas pelos cientistas?
Para chegar a essa conclusão robusta, os pesquisadores analisaram uma vasta quantidade de dados genéticos e metabólicos coletados ao longo de décadas de estudos. A análise estatística rigorosa permitiu isolar os fatores que permanecem constantes em todas as formas de vida conhecidas até o momento.
A observação detalhada revelou que alguns elementos específicos são fundamentais para a aplicação dessa lei universal na natureza, destacando-se os seguintes pontos relevantes:
- A taxa de variação no tamanho das populações em relação ao tempo decorrido.
- O fluxo de energia interna necessário para manter as funções vitais básicas funcionando.
- A capacidade de resposta genética rápida diante de pressões ambientais externas severas.
Como essa descoberta pode transformar o futuro da conservação?
Com o entendimento de que a vida segue uma regra universal, os esforços para preservar a biodiversidade podem se tornar muito mais assertivos e eficientes. A modelagem matemática avançada permitirá antecipar como as espécies reagirão às mudanças climáticas globais e à perda acelerada de habitat natural.

Essa nova perspectiva coloca a humanidade um passo à frente na proteção das espécies ameaçadas, oferecendo ferramentas para intervenções biológicas mais planejadas. O conhecimento profundo sobre os ritmos fundamentais da natureza é o segredo para uma coexistência sustentável entre o homem e o meio ambiente.
Referências: A universal thermal performance curve arises in biology and ecology | PNAS